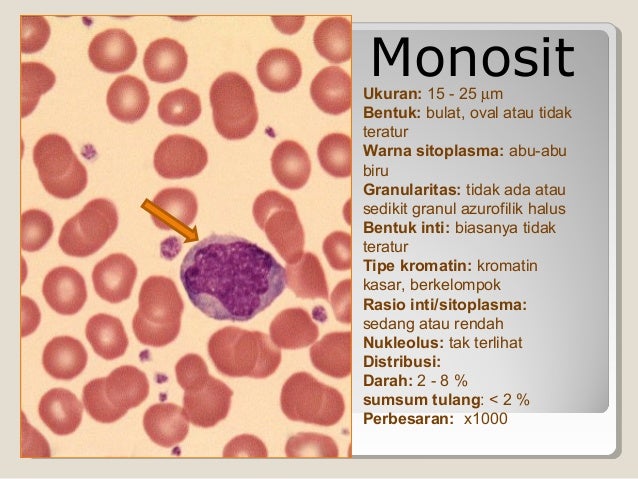

Mengenai gambar limfosit PNG
Bagaimana Limfosit Mengenali Antigen - Terapi Sehat : Info Kesehatan - Bermacam sosmed buat berbagi foto, misalnya kita tahu sosmed yang memiliki paling banyak pemakainya seperti whatsapp, instagram serta banyak aplikasi terkenal lainnya, tetapi yang paling di senangi oleh beberapa pemakai media sosial yaitu instagram, karna terdapat fiturnya dengan kegunaan yang kekinian. Jadi tidak heran kalau amat banyak yang memakai. Dengan semakin banyak memakai medsos maka hal- hal kreatifitas penggunanya pun bermunculan kayak dengan membuat foto gambar makanan untuk foto profil di sosial media. Pastinya banyak sekarang foto gambar makanan keren yang ada di medsos.Mengapa kalian perlu merubah foto gambar makanan untuk hp. Sebab menurut kami, penampilan dalam hp Android, merupakan suatu bagian yang amat penting. Setiap saat Anda menggunakan handphone entah itu untuk chat, bermain media sosial, bermain game, membuka youtube dan lain-lain. tentu kita akan kerap memandang layar handphone kita, jika wallpapernya bagus serta indah maka kalian tentunya akan enak buat melihat terus-terusan. Namun hal ini lain jika tampilan handphone Anda amat standar tidak ada sentuhan modif untuk tampilannya, hal ini rasanya akan terlihat amat menjenuhkan buat memainkan hp kita
Monosit darah makrofag leukosit tipe fungsinya tubuh. Tubuh limfosit pertahanan spesifik kekebalan jenis biologi terbentuknya perbedaan ruangguru vaksin jawaban. Limfosit sel kelainan cado catatan calon dokter ukuran. Tipe-tipe sel darah putih dan fungsinya bagi tubuh. Darah sini semuanya eosinofil
Bermacam photo gambar makanan pada hiasan smartphone Anda, pastinya kamu akan merasa senang ketika sedang menggunakan handphone kamu. Namun akan lain jadinya kalau Anda cuma mempunyai gambar gambar makanan yang hanya begitu aja. Sebab itulah yang disebut pergantian pasti dilakukan dengan cepat ataupun lambat. Pergantian ini bertujuan buat menjauhkan rasa bosan pada kamu yang hanya memiliki photo gambar makanan yang terbatas. Dari pada panjang lebar, sebab ini akan kami berikan pada kalian Bagaimana Limfosit Mengenali Antigen - Terapi Sehat : Info Kesehatan, bahkan ada juga foto gambar makanan lucu 3d ataupun foto gambar makanan kata-kata bikin ngakak yang bisa membuat hari-hari kalian gembira. foto gambar makanan dari kita pun amat pas untuk bermacam macam hp. Kalian lihat gambar gambar makanan ponsel yang telah kami kumpulkan supaya tampilan handphone kamu juga semakin bagus
Fungsi limfosit: pengertian, jenis dan ciri-ciri limfosit. Basofil leukosit neutrofil eosinofil limfosit yaitu buanget biologi. Basofil alat hematologi teknologi. Kelenjar limfe : definisi, fungsi, jenis & contoh. Limfosit sel kelainan cado catatan calon dokter ukuran. Sistem limfosit manusia tubuh kekebalan terdiri. Catatan prestasi guru biologi: sel limfosit b dan sel limfosit t
Berikut Tipe-tipe Sel Darah Putih dan Fungsinya Bagi Tubuh - myrightspot.com, Limfosit: Penyebab, Jenis, Fungsi, Nilai Normal, dll - DokterSehat terupdate tahun ini, bagi Anda yang gemar kirim gambar di medsos seperti di Facebook, instagram, Whatsapps serta media sosial lainnya diblog ini terdapat beribu koleksi photo gambar makanan paling koplak serta konyol yang kami kumpulkan dari berbagai site dan selalu posting bagi pengunjung di situs ini, yang tentunya siapapun yang melihatnya akan gembira. Baik, dibawah ini kita akan berikan mengenai foto menurut dari admin amat bagus juga untuk gambar varisi. Admin sengaja mengumplkan satu per satu gambar ini untuk di peruntukan untuk kamu semua. Silahkan saja Anda lihat terbaru yang maodif 35 foto Pendidikan | MTs Negeri Pantar | Laman 3. Pembahasanya di bawah ini:
Bagaimana Limfosit Mengenali Antigen - Terapi Sehat : Info Kesehatan

limfosit mengenali antigen bagaimana sehat kesehatan wajib milik
Limfosit: Penyebab, Jenis, Fungsi, Nilai Normal, Dll - DokterSehat

Sel B, Limfosit, Sel Gambar Png

Ca - CaDo (Catatan Calon Dokter): Blok 11 : Praktikum Patologi Klinik I

limfosit sel kelainan cado catatan calon dokter ukuran
SEMUAnya Ada Di SiNi: DARAH

sini semuanya limfosit
Limfosit, Dokumen, Sel T Gambar Png

limfosit lymphocyte dokumen pngio 2061
Sistem Kekebalan Tubuh Manusia

sistem limfosit manusia tubuh kekebalan terdiri
Basofil, Granulosit, Sel Darah Putih Gambar Png

Catatan Prestasi Guru Biologi: SEL LIMFOSIT B DAN SEL LIMFOSIT T

Fungsi Sel Darah Putih (Leukosit) Untuk Setiap Jenisnya - Update
__Limfosit__Neutofil__Dll.jpg)
Kelenjar Limfe : Definisi, Fungsi, Jenis & Contoh

limfe kelenjar limfosit
Rekayasa Genetika Kelompok 1: REKAYASA GENETIK DARI T-CELL UNTUK
limfosit sel tumor rekayasa genetika kelompok peran gonzaga biologi
Limfosit B Dan Limfosit T | MATERI | SOAL BIOLOGI SMP SMA REMBANG

limfosit sel
My Blog: Sistem Kekebalan Tubuh

imun limfosit kekebalan badan respon imunitas
Tipe-tipe Sel Darah Putih Dan Fungsinya Bagi Tubuh - Myrightspot.com

monosit darah makrofag leukosit tipe fungsinya tubuh
Fungsi Limfosit: Pengertian, Jenis Dan Ciri-ciri Limfosit | Hisham.id

limfosit ciri fungsi pengertian hisham interferon
Biologi Kelas 11 | Perbedaan Sistem Pertahanan Tubuh Spesifik Dan

tubuh limfosit pertahanan spesifik kekebalan jenis biologi terbentuknya perbedaan ruangguru vaksin jawaban
Limfosit, Getah Bening, Sel Darah Putih Gambar Png

Pemeriksaan Hitung Jenis Leukosit (Diff Count) Metode Cara Giemsa

leukosit limfosit hitung analis giemsa
Leukosit 2

leukosit jenis hitung shift
Leukosit

leukosit biru sitoplasma
Tipe-tipe Sel Darah Putih Dan Fungsinya Bagi Tubuh - Myrightspot.com

limfosit darah tipe fungsinya
Clip_image002

Monosit, Sel, Limfosit Gambar Png

BERBAGI INFO TEKNOLOGI ALAT KESEHATAN: HEMATOLOGI ANALYZER

basofil alat hematologi teknologi
BERBAGI INFO TEKNOLOGI ALAT KESEHATAN: HEMATOLOGI ANALYZER

limfosit hematologi berbagi
Limfosit B : Definisi

limfosit
My Words Is Here: MAKALAH HITUNG JENIS LEUKOSIT (DIFFERENTIAL COUNT)

SISTEM TRANSPORTASI PADA MANUSIA - Biologi Buanget

basofil leukosit neutrofil eosinofil limfosit yaitu buanget biologi
Sistem Imunitas : Pertahanan Tubuh Manusia - EDUBIO

limfosit neutrofil darah imunitas tubuh antibodi pengertian biru leukosit antigen sistem pertahanan manusia eosinofil plasma kekebalan aktif biologi salah terus
Jenis Sel Darah Putih: Basofil, Eosinofil, Neutrofil, Limfosit Dan Monosit

darah eosinofil neutrofil limfosit jenis basofil monosit pinterpandai ilustrasi
SEMUAnya Ada Di SiNi: DARAH

darah sini semuanya eosinofil
Leukosit
leukosit limfosit
Pendidikan | MTs Negeri Pantar | Laman 3

limfosit leukosit sel
Analis Kesehatan: Sel Darah Putih (Leukosit)

lymphocyte limfosit basophil flashcards quizlet eosinophil proprofs hematology oncology analis kesehatan leukosit histology cram biru monocyte endocrine
Limfosit hematologi berbagi. Tubuh limfosit pertahanan spesifik kekebalan jenis biologi terbentuknya perbedaan ruangguru vaksin jawaban. Semuanya ada di sini: darah. Leukosit limfosit hitung analis giemsa. Sistem limfosit manusia tubuh kekebalan terdiri. Catatan prestasi guru biologi: sel limfosit b dan sel limfosit t. Biologi kelas 11. Analis kesehatan: sel darah putih (leukosit). Fungsi sel darah putih (leukosit) untuk setiap jenisnya. Pemeriksaan hitung jenis leukosit (diff count) metode cara giemsa
Post a Comment for "Mengenai gambar limfosit PNG"